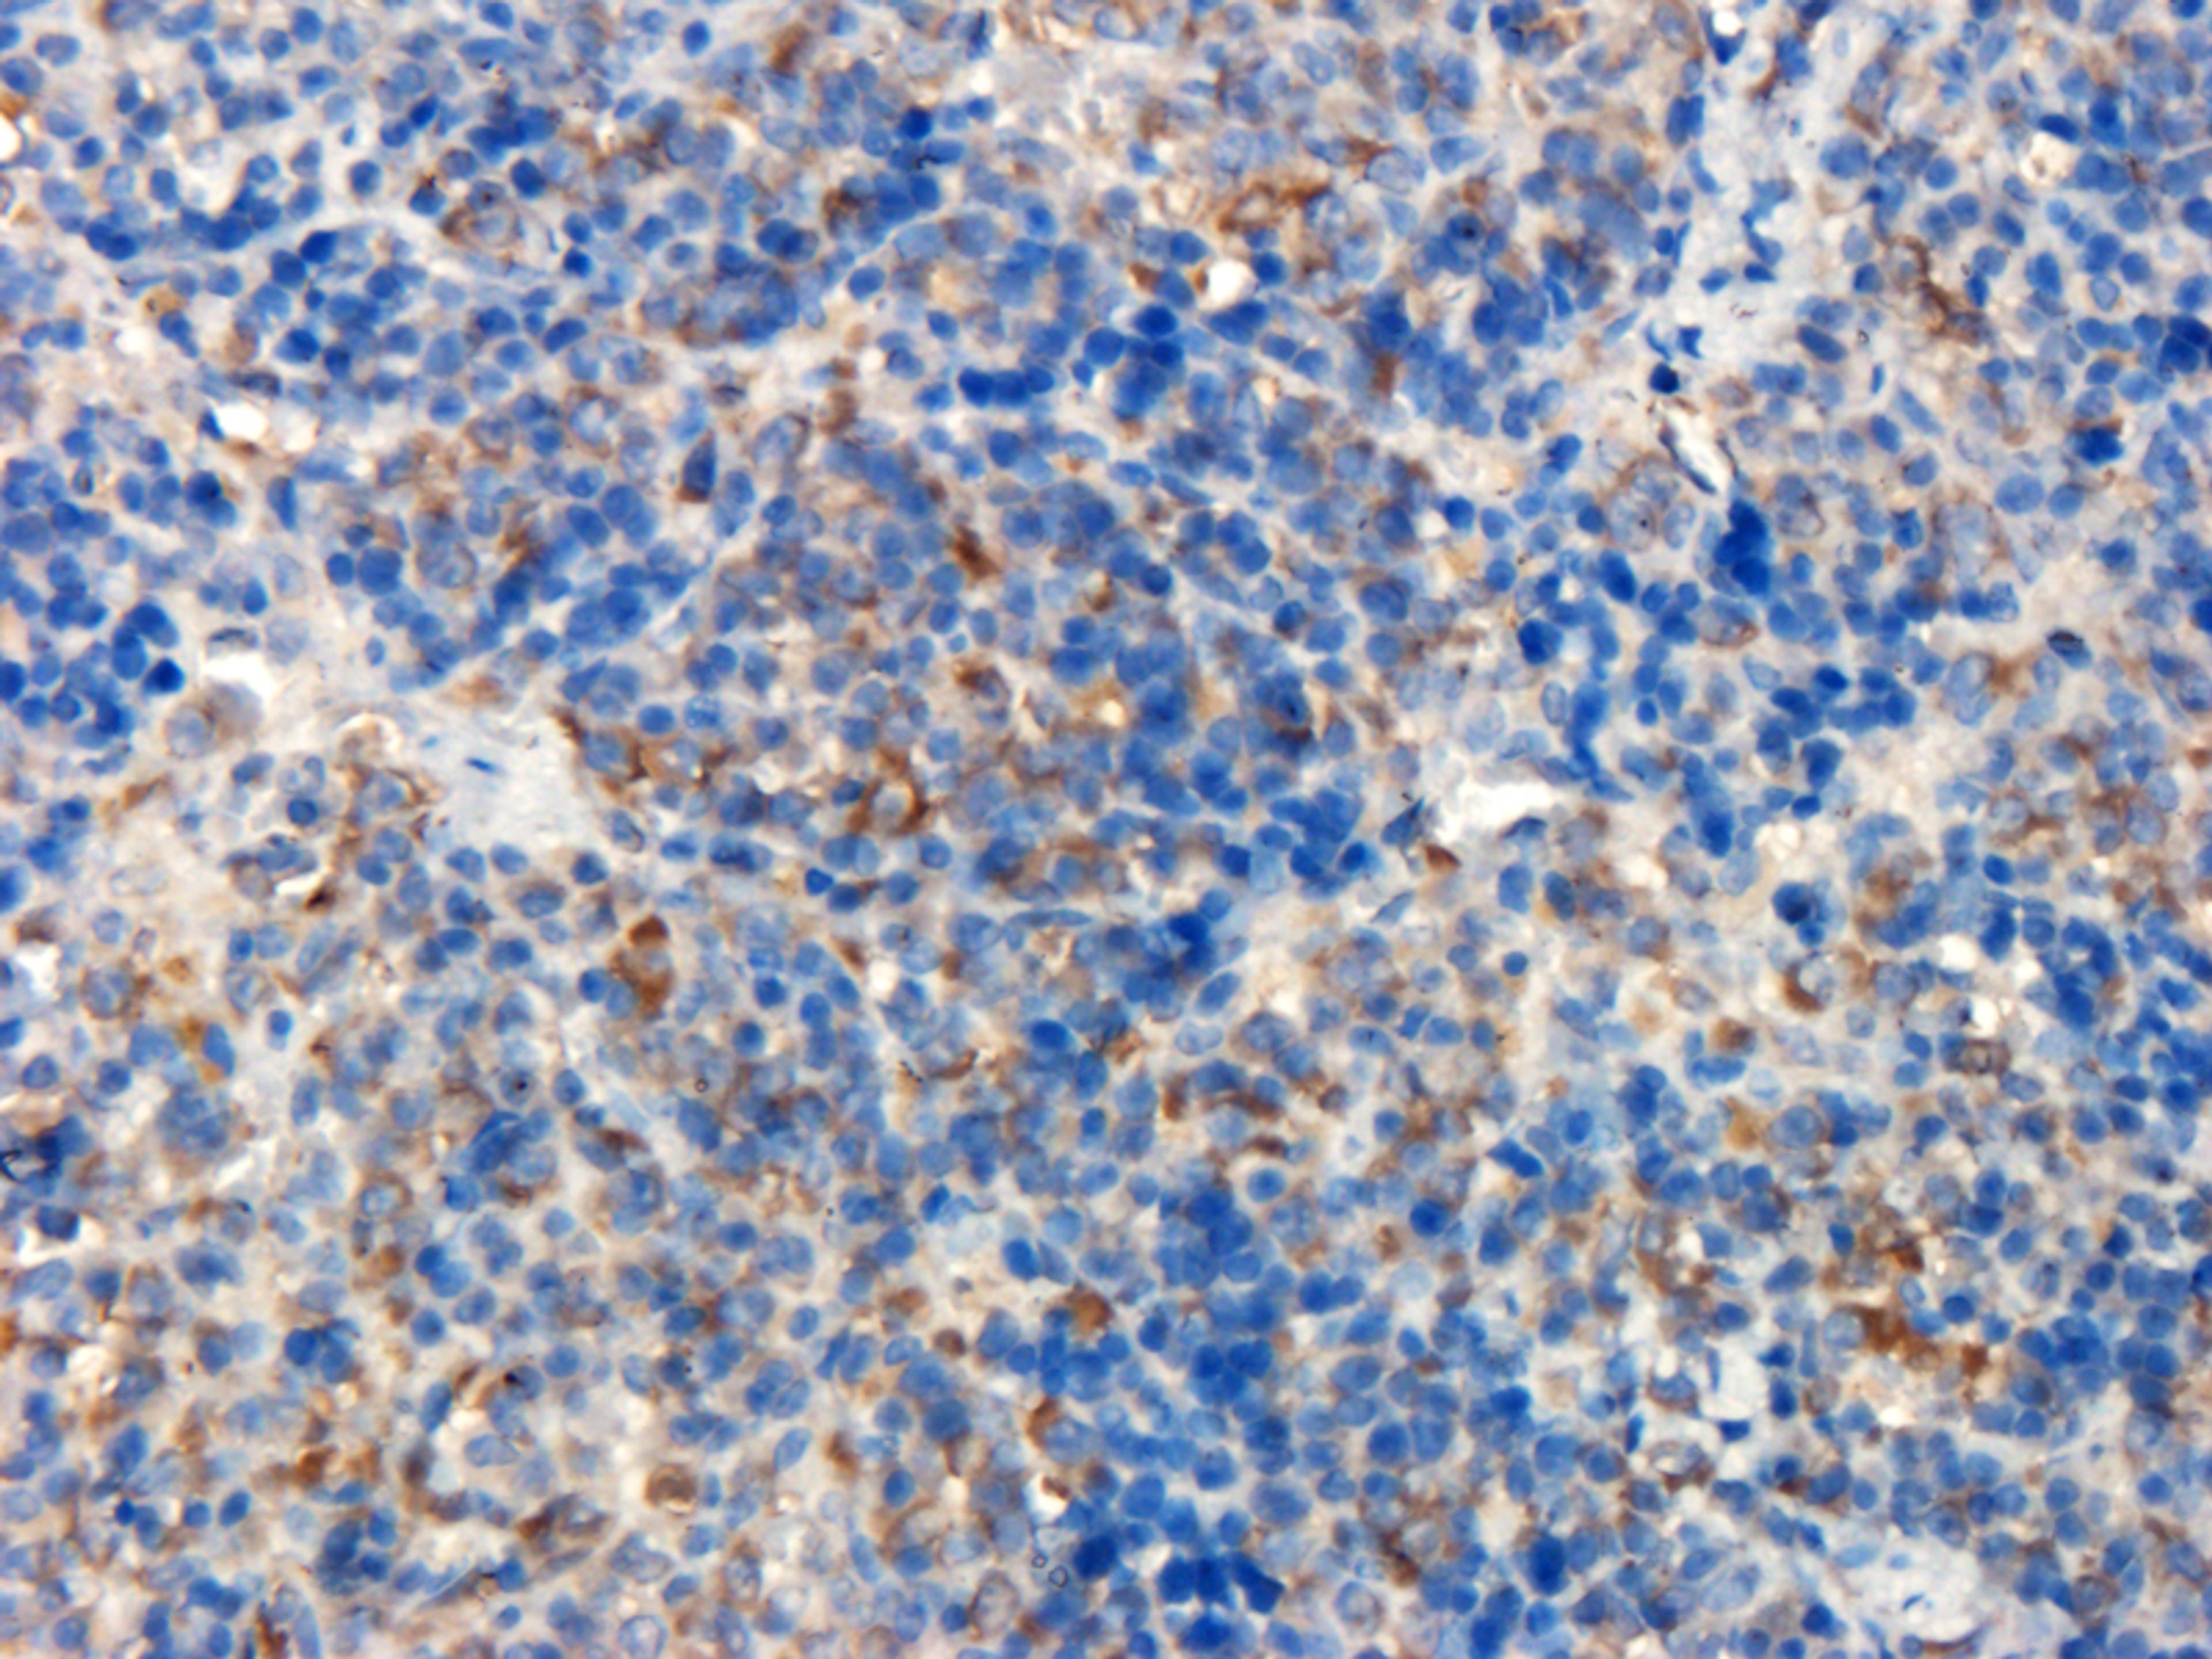
Immunohistochemical staining of paraffin embedded rat spleen tissue using anti-BMP2 (primary antibody at 1:200)

BMP2 antibody
Product Details
- Cat. No.
- orb251474
- Type
- Primary Antibody
- Clonality
- Polyclonal
- Host
- Rabbit

The supplier does not provide quotations for this antibody through SelectScience. You can search for similar antibodies in our Antibody Directory.
Description
Rabbit polyclonal antibody to BMP2 also known as bone morphogenetic protein 2 and it belongs to TGF-beta family which is expressed in the prostate as well as the ovarian duct but is highly expressed in the spleen and colon. It is found in the BMP receptor complex. This protein can Induce cartilage and bone formation. It stimulates the differentiation of myoblasts into osteoblasts via the EIF2AK3-EIF2A- ATF4 pathway. BMP2 activation of EIF2AK3 stimulates phosphorylation of EIF2A which leads to increased expression of ATF4 which plays a central role in osteoblast differentiation. In addition; it also stimulates TMEM119; which upregulates the expression of ATF4.
Biological Information
- Clonality: Polyclonal
- Host: Rabbit
- Reactivity: Chicken, Cow, Human, Mouse, Rat
- Clone: NULL
- Conjugate: Unconjugated
- Isotype: IgG
- Gene: 650
Handling
- Quantity: 100 ?g; 200 ?g
- Storage: Store at 4°C for up to two weeks. For long term storage; aliquot and store at -20°C; avoid freeze/thaw cycles.
- Buffer: 10 mM PBS; 0.02% sodium azide
Applications
- ELISA (ELISA)
- Immunofluorescence (IF)
- Immunohistochemistry (Paraffin-Embedded Sections) (IHC (P))